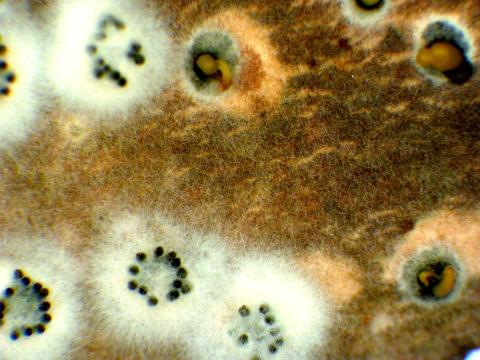
Cytospora_sp_1

Identificateur
Mario Tesolin
Crédit photo
Laboratoire d'expertise et de diagnostic en phytoprotection - MAPAQ
Fournisseur
Laboratoire d'expertise et de diagnostic en phytoprotection
Photographe
Mario Tesolin
Légende
Pycnides noires de Cytospora sp. et cirrhes orangés (Stéréomicroscope)
OrganisationFournisseur
MAPAQ - Direction de la phytoprotection (DP)